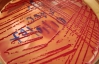

Іспанський клуб "Севілья" в сезоні 2011/2012 буде виступати у формі, на рукаві який розміщена нашивка з визнанням в любові до огірків - I love pepinos.
Про це в п'ятницю, 15 липня, повідомляють місцеві ЗМІ.
Таким чином "Севілья" висловила підтримку андалусійскім виробникам овочів, який серйозно постраждали після спалаху в Європі епідемії кишкової палички E. Coli. Від неї вже померли майже 50 осіб.
Виробники овочів серйозно постраждали через повідомлення, що з'явилися в Німеччині про те, що джерелом E. Coli є іспанські огірки. Ці звинувачення привели до різкого падіння попиту на овочі з цієї країни.
Пізніше німецькі фахівці визнали, що в огірках,які ввезені з Іспанії, немає кишкової палички. Проте, за ті кілька тижнів, поки тривав скандал, виробники овочів втратили мільйони євро.
Андалусія, яку і представляє "Севілья", є головним сільськогосподарським регіоном Іспанії.

Коментарі